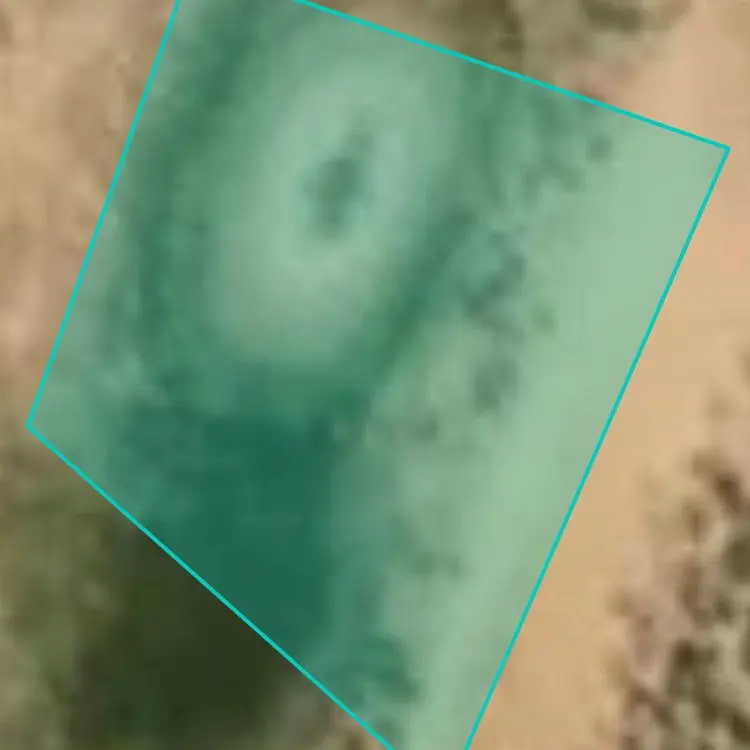

Popular Fishing Spots Near Orejas Tank

Eagle Nest Lake
30.1 mi away • Colfax County, New Mexico
36
Catches

Rio Grande
4.2 mi away • Taos County, New Mexico
15
Catches

Eagle Rock Lake
24.3 mi away • Taos County, New Mexico
14
Catches

Pioneer Creek Spill-Off
30.2 mi away • Red River, New Mexico
9
Catches

Hopewell Lake
32 mi away • Rio Arriba County, New Mexico
7
Catches

Monte Verde Lake
28.4 mi away • Angel Fire, New Mexico
6
Catches

Cimarron River
33 mi away • Colfax County, New Mexico
6
Catches

Abiquiu Reservoir
36.6 mi away • Rio Arriba County, New Mexico
6
Catches